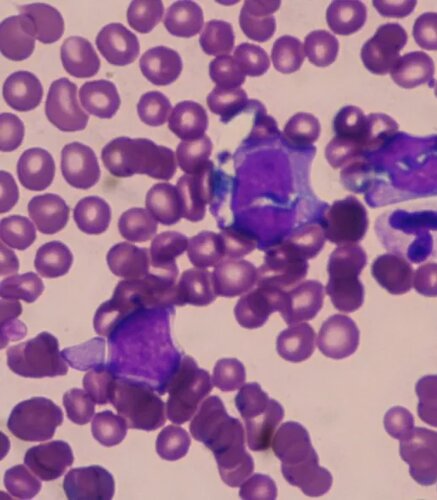
img.lte2ntu2ode1mdi 792w

Medicina Interna e Laboratorio
Servizi di Diagnostica
Veterinaria e Laboratorio
Presso il nostro ambulatorio si effettuano visite cliniche internistiche con possibilità di effettuare gran parte degli esami di laboratorio direttamente nella struttura:
- ESAME EMOCROMOCITOMRETICO
- ESAME SANGUE BIOCHIMICO COMPLETO
- TEST RAPIDI, PROFILI COAGULATIVI
- PROFILI D’ORGANO
- PROFILO ELETTROLITICO
- MEDICINA INTERNA: ESAMI DI LABORATORIO IN LOCO
- ECOGRAFIA
- RADIOLOGIA DIGITALE E PREVENTIVA SENZA L’ULTIZZO DI PELLICOLE
- CENTRO DI REFERENZA FSA (FONDAZIONE SALUTE ANIMALE)
- MEDICINA PREVENTIVA: ESAMI SCREENING PERSONALIZZATI
- OFTALMOLOGIA: MISURA DELLA PRESSIONE OCULARE ATTRAVERSO ATTREZZATURE ALL’AVANGUARDIA
- DERMATOLOGIA E CITOPATOLOGIA DIAGNOSTICA: CITOLOGIA IN TEMPO REALE E BIOPSIE
- ODONTOSTOMATOLOGIA
- NEUROLOGIA CLINICA
- CARDIOLOGIA CLINICA: MONITORAGGIO HOLTER 24/48H
- DIETOLOGIA E NUTRIZIONE
- MEDICINA DEGLI ANIMALI ESOTICI
- EDUCAZIONE CINOFILA DEI CUCCIOLI

Diagnostica per Immagini
L’ambulatorio disponde di apparecchiature per radiologia digitale di alta qualità attraverso un sistema CR indiretto, senza utilizzo di pellicole deteriorabili nel tempo. Si evitano quindi prolungati tempi di esposizione dell’operatore e del paziente dovuti a ripetizioni frequenti causate da errori tecnici o di sviluppo.
In oltre ci occupiamo di radiologia preventiva per l’individuazione precoce di alcune delle malattie scheletriche ereditarie più comuni come la displasia dell’ anca e del gomito.
Svolgiamo attività di ecografia internistica e ci rivolgiamo a professionisti esterni nei casi ostici per offrire sempre un servizio di qualità ed avere uno stimolante confronto con i colleghi specialisti. Si eseguono inoltre su richiesta referti radiografici ed ecografici.
